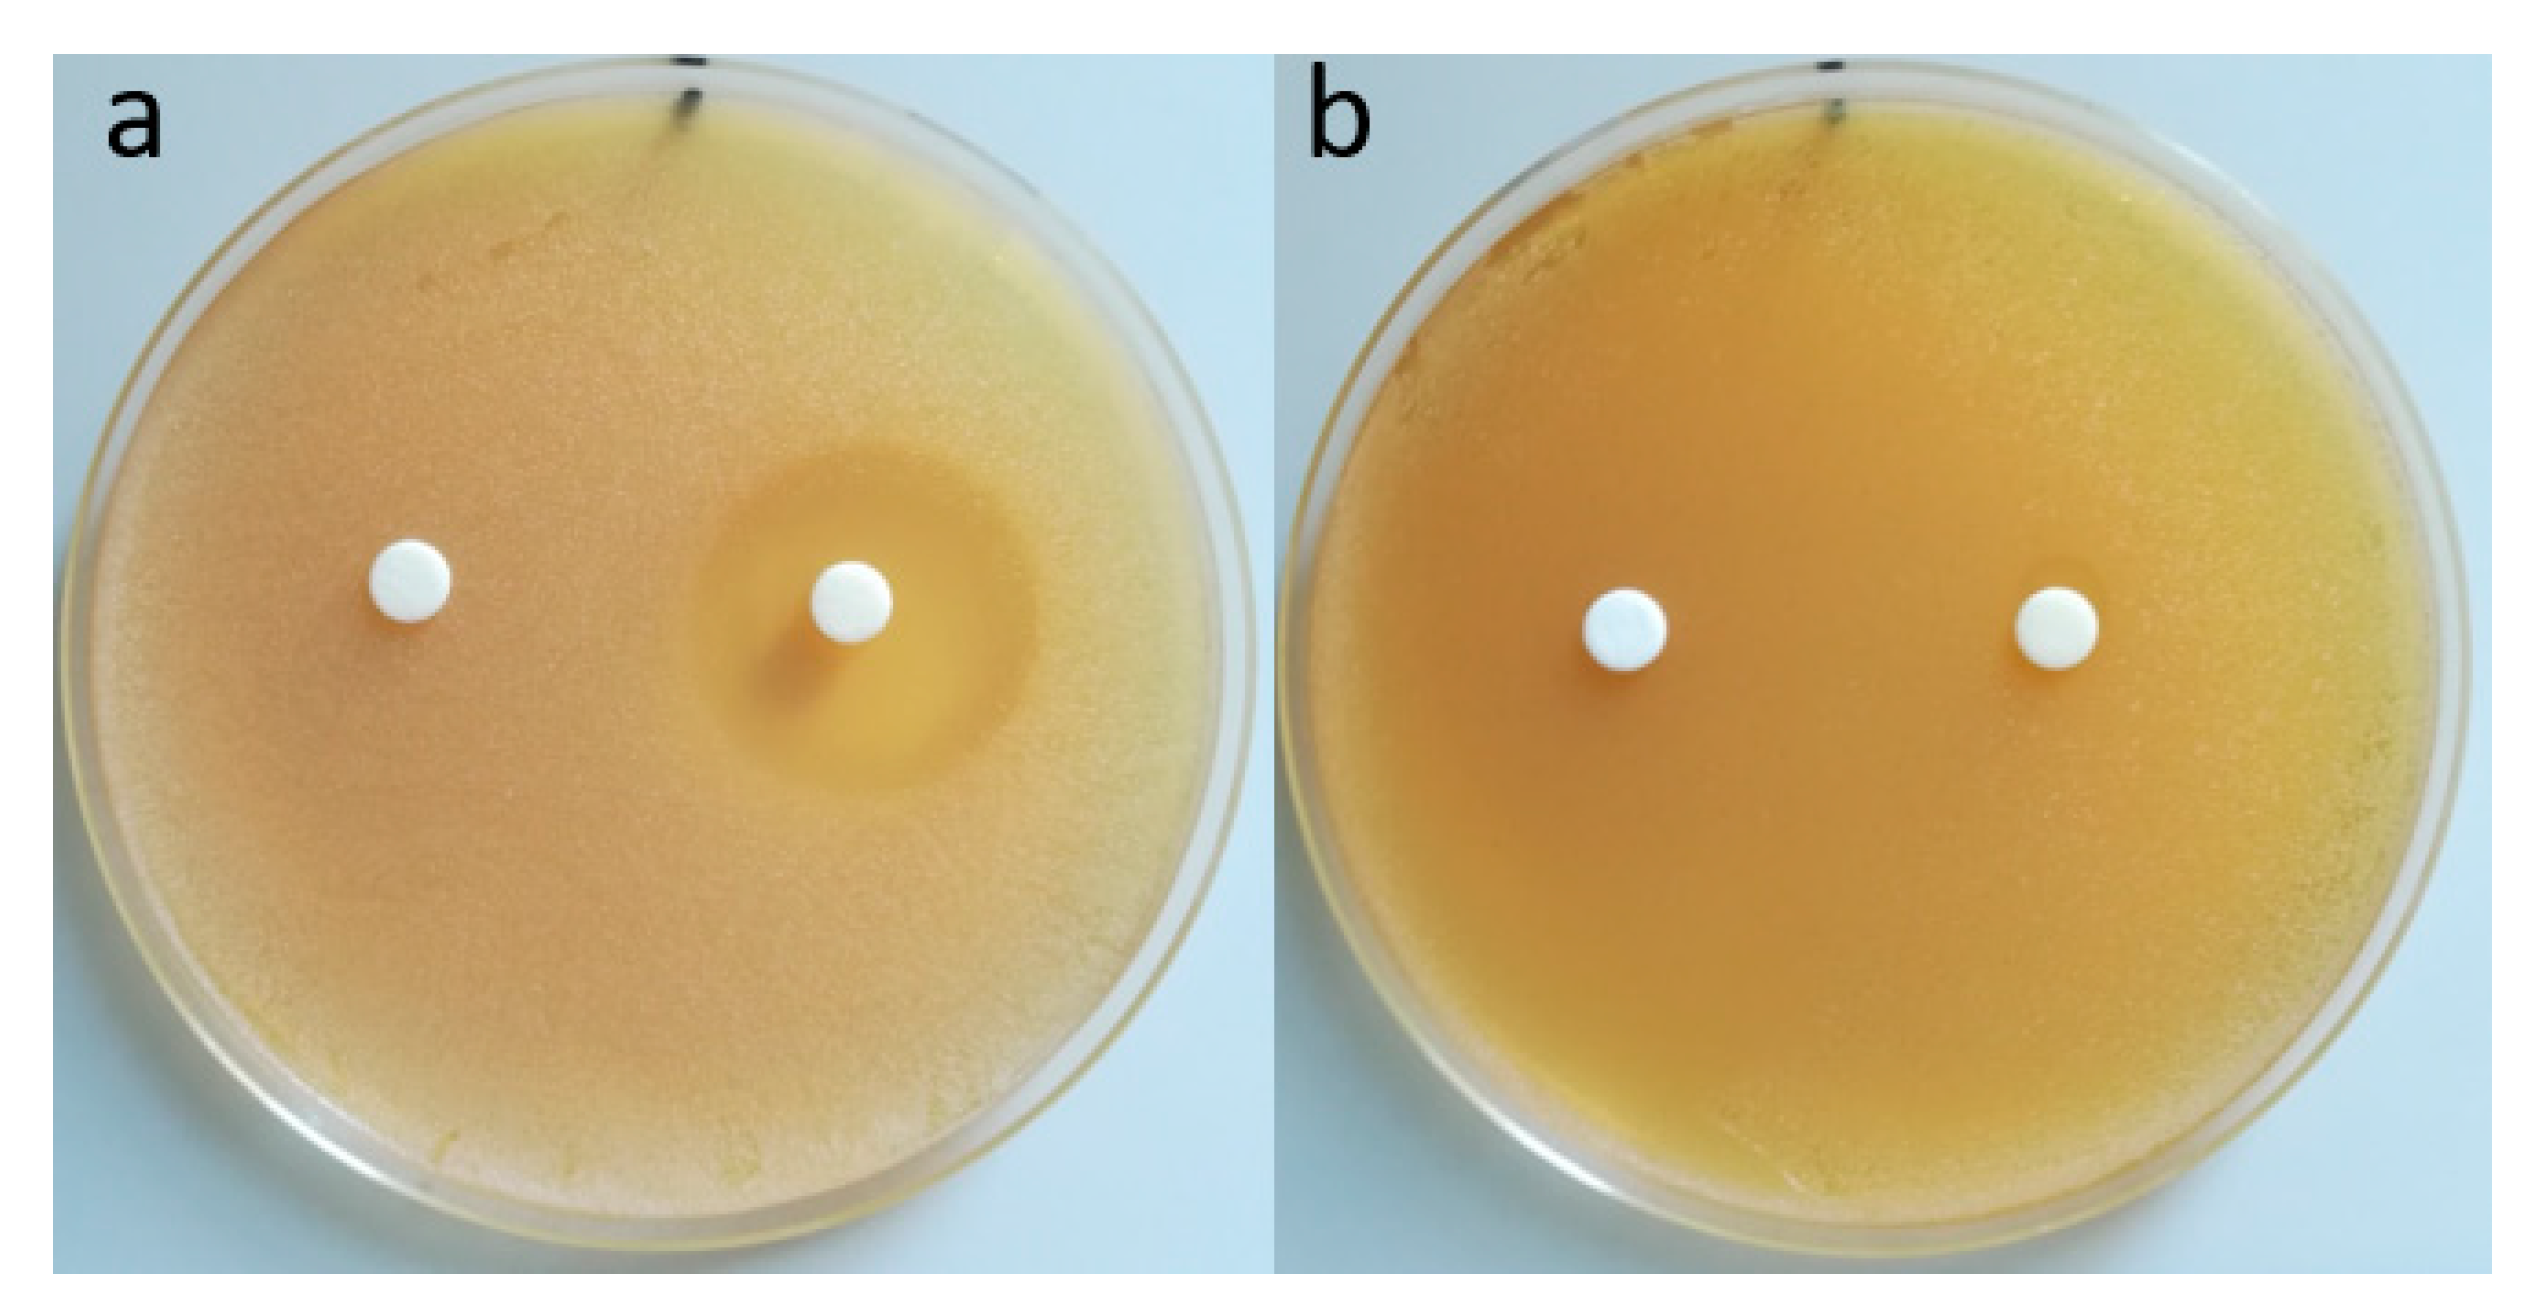
Polymers 12 02593 g011

Self-Assembled Nanocarriers Based on Modified Chitosan for Biomedical Applications: Preparation and Characterization
Abstract
1. Introduction
2. Materials and Methods
2.1. Materials
2.2. Chitosan Functionalization with MA
2.3. MAC/BSA Nanogel Preparation and Encapsulation of Amox
2.4. Turbidity Measurements of BSA/MAC Nanogels
2.5. Dynamic Light Scattering (DLS) Measurements of BSA/MAC Nanogels
2.6. Fourier Transform Infrared (FT-IR) Analysis
2.7. Morphology of the BSA/MAC Nanogels
2.8. Determination of the In Vitro Antibacterial Activity of Loaded Nanogels Using the Disk Diffusion Assay
3. Results and Discussion
3.1. Mechanism of BSA/MAC Nanogel Formation
3.1.1. Turbidity Measurements of Nanogel Solutions
3.1.2. Particle Size, PDI, and Zeta Potential Analysis by DLS
3.2. Structural Analysis of BSA/MAC Nanogels
3.3. Morphological Analysis
3.4. Investigation of pH and Temperature Sensitivity of BSA/MAC Nanogels
3.5. Antimicrobial Tests
Determination of Minimum Inhibitory Concentration (MIC) and Minimum Bactericidal Concentration (MBC)
4. Conclusions
Author Contributions
Funding
Conflicts of Interest
References
- Neamtu, I.; Rusu, A.G.; Diaconu, A.; Nita, L.E.; Chiriac, A.P. Basic concepts and recent advances in nanogels as carriers for medical applications. Drug Deliv. 2017, 24, 539–557. [Google Scholar] [CrossRef]
- Pérez-Álvarez, L.; Laza, J.M.; Álvarez-Bautista, A. Covalently and ionically crosslinked chitosan nanogels for drug delivery. Curr. Pharm. Des. 2016, 22, 3380–3398. [Google Scholar] [CrossRef]
- Debele, T.; Mekuria, S.; Tsai, H. Polysaccharide based nanogels in the drug delivery system: Application as the carrier of pharmaceutical agents. Mater. Sci. Eng. C 2016, 68, 964–981. [Google Scholar] [CrossRef]
- Elshaarani, T.; Yu, H.; Wang, L.; Ullah, R.S.; Fahad, S.; Rahman, K.U.; Khan, A.; Nazir, A.; Usman, M.; Khan, R.U.; et al. Glucose-responsive nanostructured hydrogels with enhanced elastic and swelling properties. J. Mater. Sci. 2019, 54, 10009–10023. [Google Scholar] [CrossRef]
- George, A.; Shah, P.A.; Shrivastav, P.S. Natural biodegradable polymers based nano-formulations for drug delivery: A review. Int. J. Pharm. 2019, 561, 244–264. [Google Scholar] [CrossRef]
- Borah, P.K.; Das, A.S.; Mukhopadhyay, R.; Sarkar, A.; Duary, R.K. Macromolecular design of folic acid functionalized amylopectin–albumin core–shell nanogels for improved physiological stability and colon cancer cell targeted delivery of curcumin. J. Colloid Interface Sci. 2020, 580, 561–572. [Google Scholar] [CrossRef] [PubMed]
- Wang, T.; Yang, Y.; Feng, W.; Wang, R.; Chen, Z. Co-folding of hydrophobic rice proteins and shellac in hydrophilic binary microstructures for cellular uptake of apigenin. Food Chem. 2020, 309, 125695. [Google Scholar] [CrossRef]
- Wei, Z.; Huang, Q. Assembly of Protein–polysaccharide complexes for delivery of bioactive ingredients: A perspective paper. J. Agric. Food Chem. 2019, 67, 1344–1352. [Google Scholar] [CrossRef]
- Lankalapalli, S.; Kolapalli, V.R.M. Polyelectrolyte complexes: A review of their applicability in drug delivery technology. Indian J. Pharm. Sci. 2009, 71, 481. [Google Scholar] [CrossRef]
- Quadrado, R.F.; Fajardo, A.R. Microparticles based on carboxymethyl starch/chitosan polyelectrolyte complex as vehicles for drug delivery systems. Arab. J. Chem. 2020, 13, 2183–2194. [Google Scholar] [CrossRef]
- Paşcalău, V.; Tertis, M.; Pall, E.; Suciu, M.; Marinca, T.; Pustan, M.; Merie, V.; Rus, I.; Moldovan, C.; Topala, T.; et al. Bovine serum albumin gel/polyelectrolyte complex of hyaluronic acid and chitosan based microcarriers for Sorafenib targeted delivery. J. Appl. Polym. Sci. 2020, 137, 49002. [Google Scholar] [CrossRef]
- Wang, Y.; Xu, S.; Xiong, W.; Pei, Y.; Li, B.; Chen, Y. Nanogels fabricated from bovine serum albumin and chitosan via self-assembly for delivery of anticancer drug. Colloids Surf. B Biointerfaces 2016, 146, 107–113. [Google Scholar] [CrossRef]
- Raj, L.; Jonisha, R.; Revathi, B.; Jayalakshmy, E. Preparation and characterization of BSA and chitosan nanopartices for sustainable delivery system for quercetin. J. Appl. Pharm. Sci. 2015, 5, 001–005. [Google Scholar] [CrossRef]
- Iftime, M.M.; Irimiciuc, S.A.; Agop, M.; Angheloiu, M.; Ochiuz, L.; Vasincu, D.A. Theoretical multifractal model for assessing urea release from chitosan based formulations. Polymers 2020, 12, 1264. [Google Scholar] [CrossRef]
- Zhao, J.; Li, J.; Jiang, Z.; Tong, R.; Duan, X.; Bai, L.; Shi, J. Chitosan, N,N,N-trimethyl chitosan (TMC) and 2-hydroxypropyltrimethyl ammonium chloride chitosan (HTCC): The potential immune adjuvants and nano carriers. Int. J. Biol. Macromol. 2020, 154, 339–348. [Google Scholar] [CrossRef]
- Luo, Q.; Han, Q.; Wang, Y.; Zhang, H.; Fei, Z.; Wang, Y. The thiolated chitosan: Synthesis, gelling and antibacterial capability. Int. J. Biol. Macromol. 2019, 139, 521–530. [Google Scholar] [CrossRef]
- Ghaffari, S.-B.; Sarrafzadeh, M.-H.; Salami, M.; Khorramizadeh, M. A pH-sensitive delivery system based on N-succinyl chitosan-ZnO nanoparticles for improving antibacterial and anticancer activities of curcumin. Int. J. Biol. Macromol. 2020, 151, 428–440. [Google Scholar] [CrossRef]
- Hou, X.; Zhang, W.; He, M.; Lu, Y.; Lou, K.; Gao, F. Preparation and characterization of β-cyclodextrin grafted N-maleoyl chitosan nanoparticles for drug delivery. Asian J. Pharm. Sci. 2017, 12, 558–568. [Google Scholar] [CrossRef]
- Tazhbayev, Y.; Mukashev, O.; Burkeyev, M.; Lozinsky, V.I. Synthesis and comparative study of nanoparticles derived from bovine and human serum albumins. Polymers 2020, 12, 1301. [Google Scholar] [CrossRef]
- Fathi, M.; Zangabad, P.S.; Aghanejad, A.; Barar, J.; Erfan-Niya, H.; Omidi, Y. Folate-conjugated thermosensitive O-maleoyl modified chitosan micellar nanoparticles for targeted delivery of erlotinib. Carbohydr. Polym. 2017, 172, 130–141. [Google Scholar] [CrossRef]
- Zhu, A.; Lu, Y.; Pan, Y.; Dai, S.; Wu, H. Self-assembly of N-maleoylchitosan in aqueous media. Colloids Surf. B Biointerfaces 2010, 76, 221–225. [Google Scholar] [CrossRef]
- Rusu, A.G.; Chiriac, A.P.; Nita, L.E.; Rosca, I.; Pinteala, M.; Mititelu-Tartau, L. Chitosan derivatives in macromolecular co-assembly nanogels with potential for biomedical applications. Biomacromolecules 2020, in press. [Google Scholar]
- Songsurang, K.; Pakdeebumrung, J.; Praphairaksit, N.; Muangsin, N. Sustained release of amoxicillin from ethyl cellulose-coated amoxicillin/chitosan–cyclodextrin-based tablets. AAPS Pharmscitech 2010, 12, 35–45. [Google Scholar] [CrossRef] [PubMed]
- Rusu, A.G.; Popa, M.I.; Ibanescu, C.; Danu, M.; Verestiuc, L. Tailoring the properties of chitosan-poly(acrylic acid) based hydrogels by hydrophobic monomer incorporation. Mater. Lett. 2016, 164, 320–324. [Google Scholar] [CrossRef]
- Rusu, A.G.; Chiriac, A.P.; Nita, L.E.; Bercea, M.; Tudorachi, N.; Ghilan, A.; Pamfil, D.; Rusu, D.; Cojocaru, F.D. Interpenetrated polymer network with modified chitosan in composition and self-healing properties. Int. J. Biol. Macromol. 2019, 132, 374–384. [Google Scholar] [CrossRef]
- Schatz, C.; Lucas, J.-M.; Viton, C.; Domard, A.; Pichot, C.; Delair, T. Formation and properties of positively charged colloids based on polyelectrolyte complexes of biopolymers. Langmuir 2004, 20, 7766–7778. [Google Scholar] [CrossRef] [PubMed]
- Boas, M.; Vasilyev, G.; Vilensky, R.; Cohen, Y.; Zussman, E. Structure and rheology of polyelectrolyte complexes in the presence of a hydrogen-bonded co-solvent. Polymers 2019, 11, 1053. [Google Scholar] [CrossRef] [PubMed]
- Aumiller, W.M.; Cakmak, F.P.; Davis, B.W.; Keating, C.D. RNA-Based coacervates as a model for membraneless organelles: Formation, properties, and interfacial liposome Assembly. Langmuir 2016, 32, 10042–10053. [Google Scholar] [CrossRef]
- Nita, L.E.; Chiriac, A.P.; Stoleru, E.; Diaconu, A.; Tudorachi, N. Tailorable polyelectrolyte protein complex based on poly(aspartic acid) and bovine serum albumin. Des. Monomers Polym. 2016, 19, 596–606. [Google Scholar] [CrossRef]
- Nita, L.E.; Chiriac, A.P.; Bercea, M.; Asandulesa, M.; Wolf, B.A. Self-assembling of poly(aspartic acid) with bovine serum albumin in aqueous solutions. Int. J. Biol. Macromol. 2017, 95, 412–420. [Google Scholar] [CrossRef]
- De Kruif, C.D.; Tuinier, R. Polysaccharide protein interactions. Food Hydrocoll. 2001, 15, 555–563. [Google Scholar] [CrossRef]
- Turgeon, S.; Beaulieu, M.; Schmitt, C.; Sanchez, C. Protein–polysaccharide interactions: Phase-ordering kinetics, thermodynamic and structural aspects. Curr. Opin. Colloid Interface Sci. 2003, 8, 401–414. [Google Scholar] [CrossRef]
- Hassanin, I.A.; Elzoghby, A.O. Self-assembled non-covalent protein-drug nanoparticles: Emerging delivery platform for anti-cancer drugs. Expert Opin. Drug Deliv. 2020, 1–22. [Google Scholar] [CrossRef]
- Borzova, V.A.; Markossian, K.A.; Chebotareva, N.A.; Kleymenov, S.Y.; Poliansky, N.B.; Muranov, K.O.; Stein-Margolina, V.A.; Shubin, V.V.; Markov, D.I.; Kurganov, B.I. Kinetics of thermal denaturation and aggregation of bovine serum albumin. PLoS ONE 2016, 11, e0153495. [Google Scholar] [CrossRef] [PubMed]
- Hu, X.; Wang, Y.; Zhang, L.; Xu, M. Construction of self-assembled polyelectrolyte complex hydrogel based on oppositely charged polysaccharides for sustained delivery of green tea polyphenols. Food Chem. 2020, 306, 125632. [Google Scholar] [CrossRef]
- Salehi, R.; Rasouli, S.; Hamishehkar, H. Smart thermo/pH responsive magnetic nanogels for the simultaneous delivery of doxorubicin and methotrexate. Int. J. Pharm. 2015, 487, 274–284. [Google Scholar] [CrossRef]
- Weldrick, P.J.; Iveson, S.; Hardman, M.J.; Paunov, V.N. Breathing new life into old antibiotics: Overcoming antibacterial resistance by antibiotic-loaded nanogel carriers with cationic surface functionality. Nanoscale 2019, 11, 10472–10485. [Google Scholar] [CrossRef]

| Samples | BSA/MAC (0.5%) Weight Ratio |
|---|---|
| 0.5BMAC100/120 * | 100:1 |
| 0.5BMAC33/120 | 33:1 |
| 0.5BMAC20/120 | 20:1 |
| 0.5BMAC13.3/120 | 13.3:1 |
| 0.5BMAC10/120 | 10:1 |
| 0.5BMAC8/120 | 8:1 |
| 0.5BMAC7/120 | 7:1 |
| 0.5BMAC6/120 | 6:1 |
| 0.5BMAC5/120 | 5:1 |
| 0.5BMAC100/180 | 100:1 |
| 0.5BMAC33/180 | 33:1 |
| 0.5BMAC20/180 | 20:1 |
| 0.5BMAC13.3/180 | 13.3:1 |
| 0.5BMAC10/180 | 10:1 |
| 0.5BMAC8/180 | 8:1 |
| 0.5BMAC7/180 | 7:1 |
| 0.5BMAC6/180 | 6:1 |
| 0.5BMAC5/180 | 5:1 |
| Samples | Mass ratio BSA/MAC (0.5%) | 20 °C | 80 °C | ||||
|---|---|---|---|---|---|---|---|
| Dh (nm) | PDI | Zeta Potential (mV) | Dh (nm) | PDI | Zeta Potential (mV) | ||
| 0.5BMAC100/1 | 100:1 | 174 | 0.233 | −21 | 168 | 0.348 | −27.1 |
| 0.5BMAC33/1 | 33:1 | 6301 | 0.718 | −19 | 255 | 0.359 | −26.3 |
| 0.5BMAC20/1 | 20:1 | 881 | 0.998 | −5 | 964 | 0.294 | −25.1 |
| 0.5BMAC13.3/1 | 13.3:1 | 807 | 0.781 | −4 | 1153 | 0.726 | −9.7 |
| 0.5BMAC10/1 | 10:1 | 940 | 0.382 | +19 | 1385 | 0.8 | +20.3 |
| 0.5BMAC8/1 | 8:1 | 822 | 0.226 | +15 | 270 | 0.408 | +24.2 |
| 0.5BMAC7/1 | 7:1 | 640 | 0.3 | +16 | 210 * | 0.169 * | +27.2 * |
| 0.5BMAC6/1 | 6:1 | 467 | 0.214 | +16.5 | 226 | 0.185 | +26 |
| 0.5BMAC5/1 | 5:1 | 110 | 0.628 | +18 | 347 | 0.498 | +27 |
| Strain | Inhibition Zone (mm) | MIC (mg/mL) | MBC (mg/mL) | |||
|---|---|---|---|---|---|---|
| 0.5BMAC7/180 | 0.5BMAC7/180 + Amox | 0.5BMAC7/180 | 0.5BMAC7/180 + Amox | 0.5BMAC7/180 | 0.5BMAC7/180 + Amox | |
| S. aureus | 0 | 28.21 ± 0.09 | Not tested | 0.83 | Not tested | 0.83 |
| E. coli | 0 | 8.37 ± 0.12 | Not tested | 0.83 | Not tested | - |
Publisher’s Note: MDPI stays neutral with regard to jurisdictional claims in published maps and institutional affiliations. |
© 2020 by the authors. Licensee MDPI, Basel, Switzerland. This article is an open access article distributed under the terms and conditions of the Creative Commons Attribution (CC BY) license (http://creativecommons.org/licenses/by/4.0/).
Share and Cite
Rusu, A.G.; Chiriac, A.P.; Nita, L.E.; Rosca, I.; Rusu, D.; Neamtu, I. Self-Assembled Nanocarriers Based on Modified Chitosan for Biomedical Applications: Preparation and Characterization. Polymers 2020, 12, 2593. https://doi.org/10.3390/polym12112593
Rusu AG, Chiriac AP, Nita LE, Rosca I, Rusu D, Neamtu I. Self-Assembled Nanocarriers Based on Modified Chitosan for Biomedical Applications: Preparation and Characterization. Polymers. 2020; 12(11):2593. https://doi.org/10.3390/polym12112593
Chicago/Turabian StyleRusu, Alina Gabriela, Aurica P. Chiriac, Loredana Elena Nita, Irina Rosca, Daniela Rusu, and Iordana Neamtu. 2020. "Self-Assembled Nanocarriers Based on Modified Chitosan for Biomedical Applications: Preparation and Characterization" Polymers 12, no. 11: 2593. https://doi.org/10.3390/polym12112593
APA StyleRusu, A. G., Chiriac, A. P., Nita, L. E., Rosca, I., Rusu, D., & Neamtu, I. (2020). Self-Assembled Nanocarriers Based on Modified Chitosan for Biomedical Applications: Preparation and Characterization. Polymers, 12(11), 2593. https://doi.org/10.3390/polym12112593

